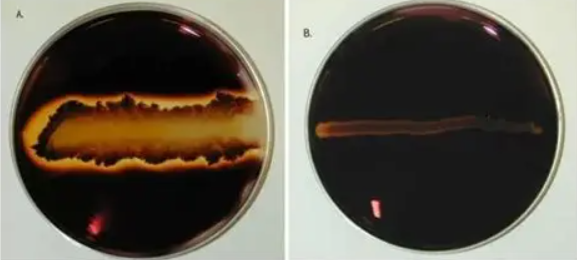
<p>Which result is positive and which one is a negative starch hydrolysis test?</p>
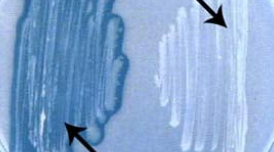
<p>Which result is positive and which one is a negative lipid hydrolysis test?</p>
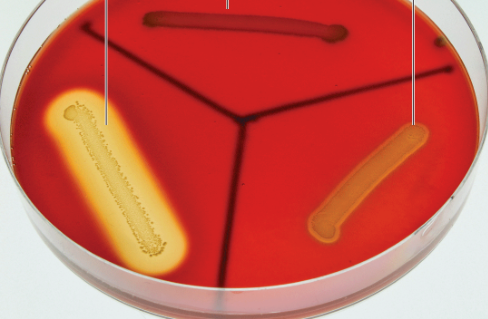
<p>How do you know if blood agar has completed lysis?</p>

Micro Lab Practical 2
1/57
There's no tags or description
Looks like no tags are added yet.
Name | Mastery | Learn | Test | Matching | Spaced | Call with Kai |
|---|
No analytics yet
Send a link to your students to track their progress
58 Terms
What is the color of Gram-positive cells
purple
What is the color of Gram-negative cells
red/pink
You are Gram staining a known sample that contains both gram-positive and gram-negative bacteria. After you complete the staining, you realize that you performed the decolorizer step for 10 minutes instead of 10 seconds! Which of the following statements would correctly explain what you see?
Gram-positive organisms might incorrectly stain red
You are Gram staining a known sample that contains both gram-positive and gram-negative bacteria. After you complete the staining, you realize that you did not use the alcohol bottle at all. Which cells would appear purple?
Gram-positive cells
Gram-negative cells
Understanding the function of the tests is more important than identifying the bacteria correctly.
True
The FTM media tells us
the oxygen requirement of the bacteria
Aerobes
require oxygen to grow
Strict Anaerobes
grow only in the absence of oxygen
Facultative anaerobes
can grow either with or without oxygen
Bacteriophage
a virus that infects bacterial cells
Virion
a single viral particle
Plaques
clearing of bacteria in a lawn due to lysis
Plaque Forming Units (PFUs)
determined by counting the number of plaques (holes) in the confluent lawn
Proteases
enzymes that degrade proteins
Gelatinase
breaks down the gelatin protein
Respiration
molecules get oxidized to form CO2 and water; ATP is generated as energy source through oxidative phosphorylation
Fermentation
molecules partially break down to alcohols and aldehydes; ATP is synthesized through substrate level phosphorylation
We know respiration has occurred if:
the catalase test produces bubbles
We know fermentation has occured if:
acids are produced in the methyl red test.
Gelitinase anabolizes gelatin.
False
Staph aureus is an opportunistic pathogen.
True
We will know our bacteria is capable of hydrolyzing fat if _____ activity is detected.
Lipase
A positive Urea Test will appear pink
True
____ is the chemical we detect to indicate tryptophanase activity.
tryptophanase
UV light can be germicidal.
True
The SM110 plate tells us:
Colony pigment
S.aureus is a halophile
True
The MSA plate tests for
fermentation of mannitol
Most bacteria are:
mesophiles
An example of an antiseptic is:
rubbing alcohol
Bleach is a disinfectant
True
S. thermophiles is active in the refrigerator.
False
Making yogurt is a form of milk preservation
True
What are the 2 main functions of a capsule?
Protection and attachment
What color does FTM (Fluid Thioglycolate Medium) turn if oxygen is present?
Pink
What are the results of a positive glucose fermentation test?
the medium in the tube will turn yellow and gas bubbles will be present
What are the results of a negative glucose fermentation test?
the medium in the tube’s color will not change and no gas bubbles are present
What are the results of a positive lactose fermentation test?
Color change (acid production)
What are the results of a positive mannitol fermentation test?
the broth would turn yellow
What are the results of a positive oxidase test?
the cotton swab turning from yellow to purple in 10-30 seconds
What are the results of a negative oxidase test?
any change over 30 seconds
What are the results of a positive catalase test?
bubbles would appear and the production of oxygen gas would be present
What are the results of a positive nitrate test?
the broth would turn dark red

Is this a positive or negative indole test?
Positive

Which one is a positive methyl red test and which one is negative?
Left is positive, right is negative

Which result is positive and which one is a negative voges-proskauer test?
left is negative, right is positive

Which result is positive and which one is a negative citrate test?
left is negative and right is positive
Which result is positive and which one is a negative starch hydrolysis test?
left is positive, right is negative
Which result is positive and which one is a negative lipid hydrolysis test?
Left is positive, right is negative

Which result is positive and which one is a negative urea hydrolysis test?
pink is positive, orange is negative

Explain the results of Kligler’s iron agar is a multiple test medium
gas is produced if there are cracks in the medium
lactose fermentation results in the slant turning yellow
hydrogen sulfide production is identified by the butt turning black
the slant turns pink/red when lactose non-fermenters are present (salmonella)
How do you know if blood agar has completed lysis?
the medium turns clear
Gram stain examples
crystal violet, grams iodine, decolorizer, safranin
S.aures
gram positive
cocci
yellow color
P.vulgaris
gram-negative
motile
rod-shaped
grey color
P.aeroginosa
gram negative
rod-shaped
green color
E.coli
white color
gram negative
rod-shaped
found in intestines
Capsule Stains
Crystal Violet
Copper Sulfate